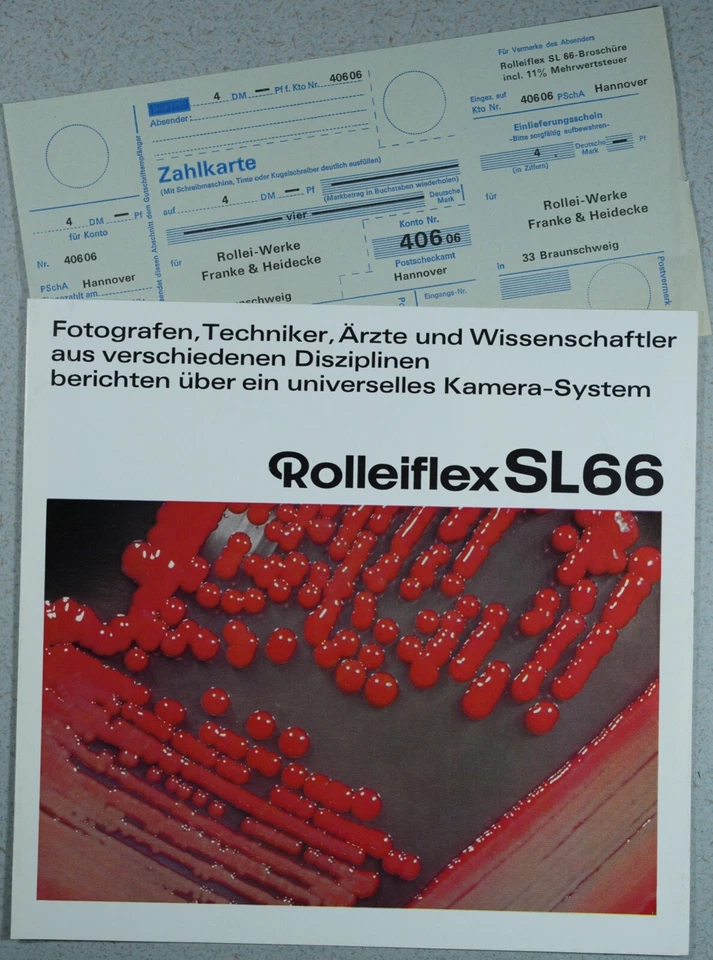
ROLLEI Rolleiflex SL66 mit PS-Zahlkarte!, Prospekt, 1969, 4 S., guter Zustand! - Image 1 of 1

Rollei Camera Manuals & Guides
Shop by category
911 results
Sort: Best Match
- RM 330.71or Best OfferRM 282.78 shipping
- Pre-Owned · RolleiRM 167.74RM 135.31 shipping
- Pre-Owned · RolleiRM 202.49or Best OfferRM 99.92 shipping
- RM 119.77or Best OfferRM 71.89 shipping
- New (Other) · RolleiRM 82.61RM 75.34 shipping
- Pre-Owned · RolleiRM 82.04RM 104.57 shipping
- Pre-Owned · RolleiRM 19.12or Best OfferRM 23.96 shipping
- RM 49.59or Best OfferRM 99.76 shipping0 bids4d 20h
- Pre-Owned · RolleiRM 43.14or Best OfferRM 23.96 shipping
- Pre-Owned · RolleiRM 27.29or Best OfferRM 25.16 shipping
- RM 107.24RM 100.67 shipping
- Pre-Owned · RolleiRM 27.89Was: RM 61.99was - RM 61.99or Best OfferRM 98.35 shipping
- RM 95.81or Best OfferRM 71.89 shipping
- Pre-Owned · RolleiRM 65.63or Best OfferRM 123.12 shipping
- Pre-Owned · RolleiRM 49.86or Best OfferRM 239.36 shipping
- RM 95.81or Best OfferRM 23.96 shipping
- Pre-Owned · RolleiRM 78.31RM 99.80 shipping
- Pre-Owned · RolleiRM 41.28RM 30.99 shipping
- Pre-Owned · RolleiRM 21.82or Best OfferRM 38.29 shipping
- Pre-Owned · RolleiRM 41.28or Best OfferRM 86.95 shipping0 bids2d 2h
- RM 103.11or Best OfferRM 75.96 shipping
- Pre-Owned · RolleiRM 65.91RM 99.43 shipping
- Pre-Owned · RolleiRM 45.42RM 30.99 shipping
- Pre-Owned · RolleiRM 34.34or Best OfferRM 91.49 shipping
- Pre-Owned · RolleiRM 2,707.34RM 243.22 shipping
- Pre-Owned · RolleiRM 301.89RM 135.31 shipping
- Pre-Owned · RolleiRM 167.74RM 135.31 shipping
- Pre-Owned · RolleiRM 35.55or Best OfferRM 113.87 shipping
- Pre-Owned · RolleiRM 297.50RM 135.31 shipping
- RM 28.71or Best OfferRM 23.96 shipping
- Pre-Owned · RolleiRM 49.38RM 98.93 shipping
- Pre-Owned · RolleiRM 36.99RM 98.56 shipping
- Pre-Owned · RolleiRM 47.45or Best OfferRM 239.16 shipping
- Pre-Owned · RolleiRM 95.38or Best OfferRM 239.16 shipping
- Pre-Owned · RolleiRM 92.82or Best OfferRM 96.08 shipping
- Pre-Owned · RolleiRM 167.74RM 135.31 shipping
- RM 95.81or Best OfferRM 71.89 shipping
- RM 278.95or Best OfferRM 71.89 shipping
- Pre-Owned · RolleiRM 108.14RM 68.75 shipping
- Pre-Owned · RolleiRM 71.41RM 42.66 shipping
- Pre-Owned · RolleiRM 54.64RM 103.59 shippingOnly 1 left!
- RM 38.30or Best OfferRM 23.96 shipping
- RM 119.82RM 88.91 shipping
- Pre-Owned · RolleiRM 71.85or Best OfferRM 43.09 shipping
- RM 33.50or Best OfferRM 23.96 shipping
- Pre-Owned · RolleiRM 103.11RM 100.54 shipping
- Pre-Owned · RolleiRM 120.65RM 38.29 shipping
- Pre-Owned · RolleiRM 100.21or Best OfferRM 239.36 shipping
- Roberts Camera - Photo Industry Leader since 1957!Pre-Owned · RolleiRM 106.08or Best OfferRM 64.30 shipping
- RM 45.42RM 74.22 shipping
- RM 71.85or Best OfferRM 43.09 shippingOnly 1 left!
- RM 28.71or Best OfferRM 38.34 shipping
- RM 95.81or Best OfferRM 43.09 shipping
- RM 147.89or Best OfferFree international shipping
- Brand New · RolleiRM 53.68RM 74.47 shippingOnly 1 left!
- RM 95.81or Best OfferRM 71.89 shipping
- Pre-Owned · RolleiRM 35.55or Best OfferRM 42.66 shipping